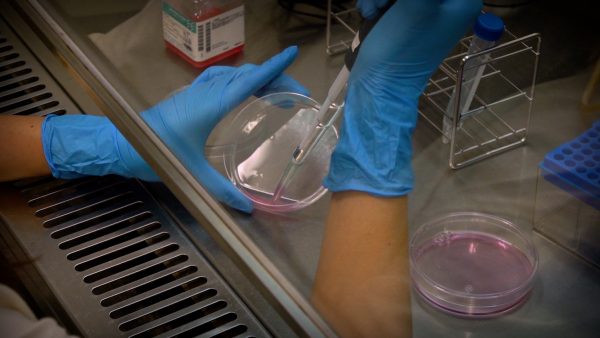

人類の究極の夢”不老不死”
紀元前の秦の始皇帝。あるいは中世の錬金術師。彼らは永遠の命を求め不老不死の薬を作り出そうとした。はるか昔から人類の究極の夢だった不老不死の妙薬。今、その夢に近づく若返りの薬の実現が、最先端の科学技術によって見えてきたという。だがそんなことは本当に可能なのか、奈良先端科学技術大学院大学の松田准教授の元を訪ねた。
老化とは何か
松田さんによると、理論的に若返りの薬の実現は可能だという。そんな松田さんが研究するのは脳の老化だ。脳に存在する海馬には、多くの神経細胞が存在し、この神経細胞が私たちの学習や記憶といった機能を支えている。つまり海馬が老化してしまうと、学習や記憶などの機能低下、そして認知症などの疾患にもつながることがあるのだ。そんな海馬の老化の鍵を握る存在が、神経幹細胞と呼ばれる細胞だった。
遺伝子のONとOFF
では海馬では、なぜ老化により神経幹細胞が減少してしまうのか。松田さんはまず、加齢に伴って遺伝子の発現がどのように変化していくかを調べた。すると細胞の機能維持に関わる遺伝子の発現低下が分かったという。遺伝子の発現はいわばONとOFF。ONであれば細胞に必要な様々なタンパク質が作られ、OFFであればそれらは作られないという。
そして老化とは遺伝子の発現が徐々にOFFになっていってしまう現象だった。
若返りの鍵となるSetd8
ではなぜ遺伝子の発現が次第にOFFになってしまうのか?それを調べるのがヒストン修飾という現象の解析だった。実は遺伝子の発現はヒストン修飾という現象によってONとOFFに切り替わるのだ。
そんなヒストン修飾を調べると、Setd8と呼ばれる酵素の存在が浮かび上がった。そして老化によって遺伝子の発現が次第にOFFになってしまう原因が明らかになるのだった。
若返りの薬は可能なのか
Setd8の発現を増やすことで、老化した細胞が機能を取り戻し若返る可能性があるということを見出した松田さんは、今更なるアプローチを検討している。それは「若返りのリプログラミング」という現象を実現させることだという。
若返りのリプログラミングとはどのような現象なのか?そして若返りの薬の実現するのだろうか?
主な取材先
松田 泰斗さん(奈良先端科学技術大学院大学)